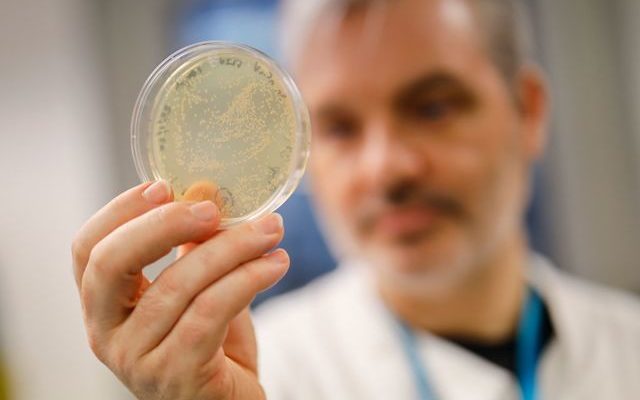

(Mike Adams) Prepare for a flood of intel in today’s Situation Update podcast shown below. Beyond the world bombshell DARPA document leaked to DRASTIC, which shows that EcoHealth Alliance and Fauci conspired to release aerosolized, skin-penetrating spike protein nanoparticles into wild bat populations in China (which would immediately leap to humans as planned), we also have bombshell intel about something else that makes it even worse.
Wuhan Lab
Ex-Communist Official Says China Intentionally Spread COVID at Int’l Event in Oct. 2019
(C. Douglas Golden) Was the first superspreader COVID-19 event at a military athletic tournament that took place two months before the first reported cases of the virus? And was it part of a Chinese bioweapons experiment?
Exposed: Wuhan Scientists Planned to Use “Skin-penetrating Nanoparticles” To Unleash “Chimeric Covid Spike Proteins” Into Bats in China
(Ethan Huff) A year and a half prior to the Wuhan coronavirus (Covid-19) making its world debut, scientists working in Wuhan, China, reportedly submitted a proposal asking to release genetically altered (GMO) coronaviruses into the wild.
BREAKING: Dr. Fauci Funded 60 Projects at the Wuhan Institute of Virology and All Were in Conjunction with the Chinese Military
(Joe Hoft) New revelations have come out about Anthony Fauci, the mad medic, Director of the National Institute of Allergy and Infectious Diseases (NIAID) and the Chief Medical Advisor to the President. This time from Australia.
Bombshell: 900 Pages Of Top Secret Docs Expose How The Pandemic Was PLANNED
(NWO Report) More than 900 pages of newly released top secret documents on the pandemic expose for the first time through official materials how the US funded deadly coronavirus research at the Wuhan lab through an organization called the EcoHealth Alliance.
Crazy Dr. Fauci – Who Funded the Wuhan Lab Research Behind COVID-19 – Wants Unvaxxed Banned from Air Travel and Pushes Vax on Little Children
(Jim Hoft) Dr. Death Tony Fauci, the man who funded the Wuhan lab research that created the coronavirus, was out spouting off again on Sunday.
Newly Released Official Documents Prove US Grants Funded Coronavirus Research at Wuhan Lab
(Dillon Burroughs) More than 900 pages of new information were released late Monday regarding U.S.-funded research at the Wuhan Institute of Virology that has raised further questions about the origins of COVID-19.
FOIA Release: Fauci Funded Construction Of ‘Chimeric Coronaviruses’ In Wuhan
(Tyler Durden) When Dr. Anthony Fauci confidently screamed at Sen. Rand Paul (R-KY) in July – calling him a liar for accusing him of funding so-called “Gain-of-Function” (GoF) research in Wuhan, China to make coronaviruses more transmissible to humans, the argument ultimately faded due to Fauci’s unsupported claim that the research didn’t technically fit the definition of GoF.
Newly Released 900 Pages in Docs Show Rand Paul Was Right: Fauci Lied About Wuhan-Lab Funding
(Kyle Becker) Newly released documents reveal in depth how the National Institute of Allergy and Infectious Disease, headed by none other than Dr. Anthony Fauci, funding the U.S.-based non-profit EcoHealth Alliance performing “high-risk” research with the Wuhan Institute of Virology in China.
Inconclusive Intel Report on Covid-19 Conclusively Proved One Thing: Censorship Is Harmful
(John Solomon) The Wuhan lab leak theory, which AP claimed to debunk and Facebook censored, got a moderate probability rating by U.S. intel, while natural evolution got a “low” confidence rating.
Sen. Rand Paul: Dr. Fauci Should Testify under Oath about Money given to Wuhan Lab
(Nolan Barton) On Wednesday, May 26, Republican Sen. Rand Paul of Kentucky called on National Institute of Allergy and Infectious Diseases (NIAID) Director Dr. Anthony Fauci to testify under oath about whether the NIAID funded scientists at the Wuhan Institute of Virology (WIV) to do gain-of-function research. This is a risky area of study that makes viruses even more contagious.
Ahead of Biden’s Coronavirus Origins Report, China Vows to Retaliate If Blamed for Wuhan Lab Leak
(Kyle Becker) China is definitely not guilty. It is so not guilty of performing gain-of-function research on a novel coronavirus at the Wuhan Institute of Virology and leaking it around the world that it is now issuing the threatening statement: Blame us for the Wuhan lab leak and we will retaliate.
WHO COVID Investigator FINALLY Admits Wuhan Lab Leak Theory Is ‘Probable’.
(Natalie Winters) The lead investigator for the World Health Organization’s COVID-19 origins team admitted that the virus developing as a result of a Wuhan Institute of Virology employee getting infected by a bat was a “probable hypothesis.”
BOMBSHELL REPORT: Lab Leak and “Frantic” Chinese Cover-Up Happened Earlier Than Thought
(Leisa Audette) Republicans just confirmed what so many have known. The Chinese are responsible for the deaths of millions around the world. Their cover-up helped spread the virus. President Trump proposed that China should pay for their cover-up, but Biden has done nothing.
BOMBSHELL: Former National Intelligence Director Says ‘Every Piece Of Evidence’ Proves COVID-19 Leaked From Wuhan Lab.
(Natlie Winters) Former Director of National Intelligence John Ratcliffe asserted that “every piece of evidence” he witnessed – including the “most sensitive intelligence” – demonstrates that COVID-19 originated in the Wuhan Institute of Virology.